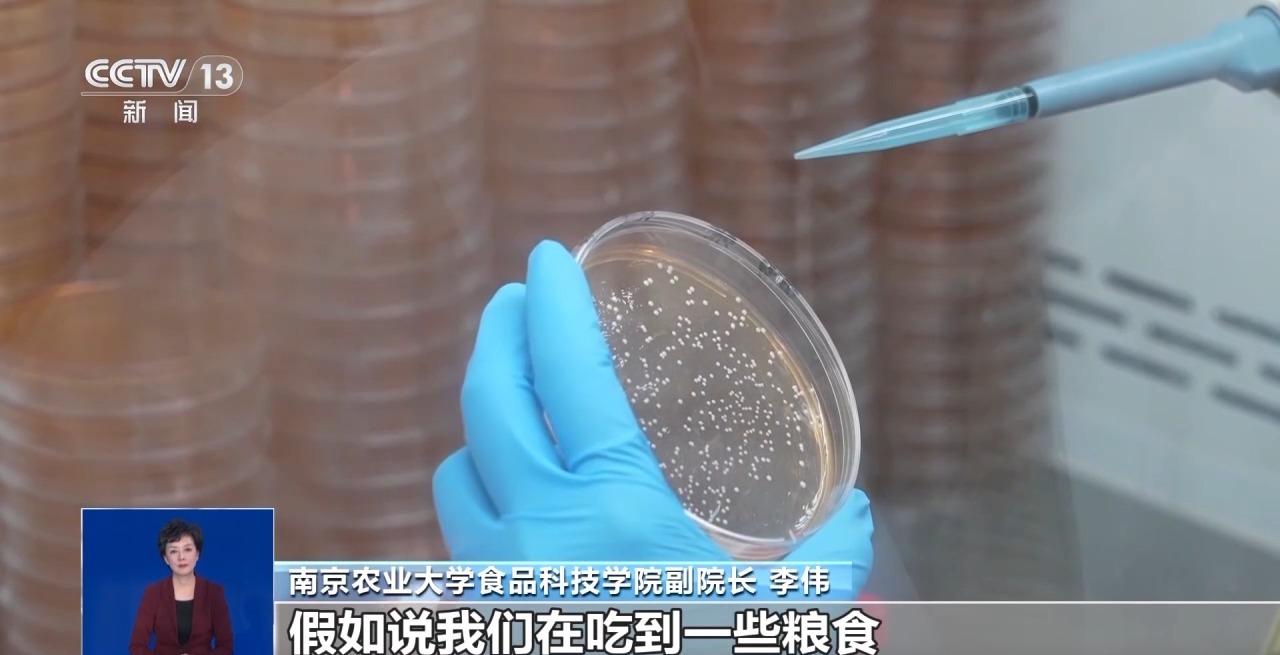

近日,网上流传出一则视频,声称冷冻馒头不能吃了,因为冷冻超过两天会长出毒性堪比“砒霜”的黄曲霉素!那么,馒头冻上两天真的会长黄曲霉素吗?冻馒头真的是成了“致癌餐”了?接下来我们一起还原事实,洞悉真相。
冷冻环境不适宜黄曲霉毒素的生长
馒头冷冻两天真的会长黄曲霉素吗?就此问题,记者采访了南京农业大学的相关专业人员。
南京农业大学食品科技学院副院长李伟:黄曲霉毒素是黄曲霉菌产生的次生代谢产物,一种毒素。
专家介绍,通常食物的温度和湿度要达到一定的条件,才会产生黄曲霉素,冷冻或冷藏的环境都不适宜黄曲霉素的生长。

南京农业大学食品科技学院副院长李伟:冷冻的条件是非常不适合黄曲霉菌生长代谢,或者产生毒素的条件。如果要产生黄曲霉毒素,一般要满足几个条件,第一要有比较适宜的温度,通常霉菌适宜的温度从15℃到35℃,是它比较适合生长的温度。另外霉菌的生长需要有湿度,湿度也是比较高的,80%到90%的湿度。

据了解,一般家用冰箱的冷冻温度在零下18摄氏度,湿度也相对较低。因此,并不满足黄曲霉菌产生毒素的条件。对此,专家辟谣表示,这种说法过分夸大了冷冻馒头可能的风险。
浙大回应网传短视频:没有相关研究
网上流传的这个视频据称来自——浙大研究发现,那么,这是不是浙大研究团队的科研结果呢?今天记者采访了浙江大学生物系统工程与食品科学学院副院长刘东红。
浙江大学生物系统工程与食品科学学院副院长 刘东红:浙江大学一直非常关注食品安全领域的研究工作,也非常关心微生物导致的致病性食用菌的安全的研究工作,但是浙江大学没有做过冷冻馒头产生黄曲霉毒素的研究。因为我看到网上一年前也有过类似的报道,还有更早的时候也有。这些报道都打着不同学校的名义,显然说明报道是不真实的。
新闻链接:黄曲霉毒素有多毒?
据专家介绍,其实黄曲霉菌本身是没有毒的,但是它产生的黄曲霉毒素却是有毒的。那么,毒性到底有多强呢?食用哪些食物容易“中招”?我们一起来了解。

黄曲霉毒素是黄曲霉和寄生曲霉的代谢产物,是迄今发现的毒性和致癌性最强的真菌毒素之一。目前,已发现的黄曲霉毒素及其衍生物大约20种,其中以黄曲霉毒素B1最常见,其毒性约为砒霜的68倍。特别值得一提的是,黄曲霉毒素耐高温,裂解温度是280℃。所以,日常烹饪的温度(100℃~200℃)根本奈何不了它,也不要指望开水煮或者油烹能把它杀灭。

黄曲霉毒素不仅“毒”,而且广泛存在于日常生活中,那么哪些食物易被污染呢?
第一类是发霉的谷物,包括大米、小米、玉米、豆类等淀粉含量高的谷物;
第二类就是发霉的花生及坚果,因为花生及坚果富含油脂,且黄曲霉毒素溶于油脂,所以它们易感染黄曲霉菌。
第三类是木制砧板、木筷子。砧板及筷子的缝隙中易藏匿食物残渣,如使用后清洁不到位,或长时间放置在潮湿阴暗的角落,就容易产生霉变。
如何防范霉素风险?面食如何正确保存?
黄曲霉素的主要来源是哪儿?该如何防范?

南京农业大学食品科技学院副院长李伟:对于黄曲霉菌,它也有一些非常喜欢的宿主,特别是玉米和花生。霉菌长了毒素以后,因为它有基内的菌丝,实际上菌丝或者毒素不仅可以深入食品的表面,还会深入到内部。因为有的时候无法从颜色上观察菌丝渗透深浅。
南京农业大学食品科技学院副院长李伟:一般情况下,如果品尝到粮食或者花生有异味,这个时候不要仅仅把这个东西吐掉,而且还要用水大量涮口腔,我们吃到的苦味都和一些毒素的产生或者不好的物质有密切关系。
新鲜的馒头或者面食没有吃完,应该如何正确保存?

南京农业大学食品科技学院副院长李伟:长期存放要放在冷冻的环境,三个月内吃完。如果放在冷藏的条件下,可以拿保鲜膜把它包起来,再把它放在保鲜袋里面。在放之前最好不要用手或者跟周围环境接触太多。
新闻链接:当心隐形致毒“霉菌”藏在食物里
除了刚才提到的坚果类和谷物类。其实还有一些食物,保存不当也容易产生“隐形”致癌毒素。
生姜

生姜是厨房里常见的调味品。由于使用量非常小,很容易腐烂变质。老话常说“烂姜不烂味”,意思是姜腐烂了也能继续吃。这种说法对吗?对此,专家提醒,生姜放置过久很容易霉变,增加致癌风险。腐烂的生姜中的黄樟素是一种致癌物,已经被世界卫生组织列为2B类致癌物。

那把生姜坏掉的部分切掉后还能不能吃呢?答案是不能。因为即便切掉坏的部分,但肉眼看不到的地方还可能有霉菌毒素,即便经过高温烹煮,也很难杀死。
甘蔗
眼下正是甘蔗上市的季节。前不久,杭州的王女士晚饭后吃甘蔗时,发现味道不太对:吃起来不脆、有些发糠,甜中略带着一股酒酸味,随后开始拉肚子,甚至陷入昏迷被送往医院紧急抢救。经诊断,王女士是食用霉变甘蔗中毒。

生活中有人常以为甘蔗内部变红会变得更甜,其实甘蔗出现“红心”“黑心”是因为其受到了霉菌污染。因为甘蔗的含糖量比较高、水分含量也十分充足,虽其果皮坚硬,但它在收获时往往存在切口,果肉会暴露出来,所以易受储存和运输环境的影响,存在被霉菌污染的风险。其中——节菱孢霉菌堪称危险的“杀手”,这种霉菌在生长繁殖过程中会产生一种剧毒的毒素——3-硝基丙酸。所以,提醒大家,请勿食用“红心”甘蔗!